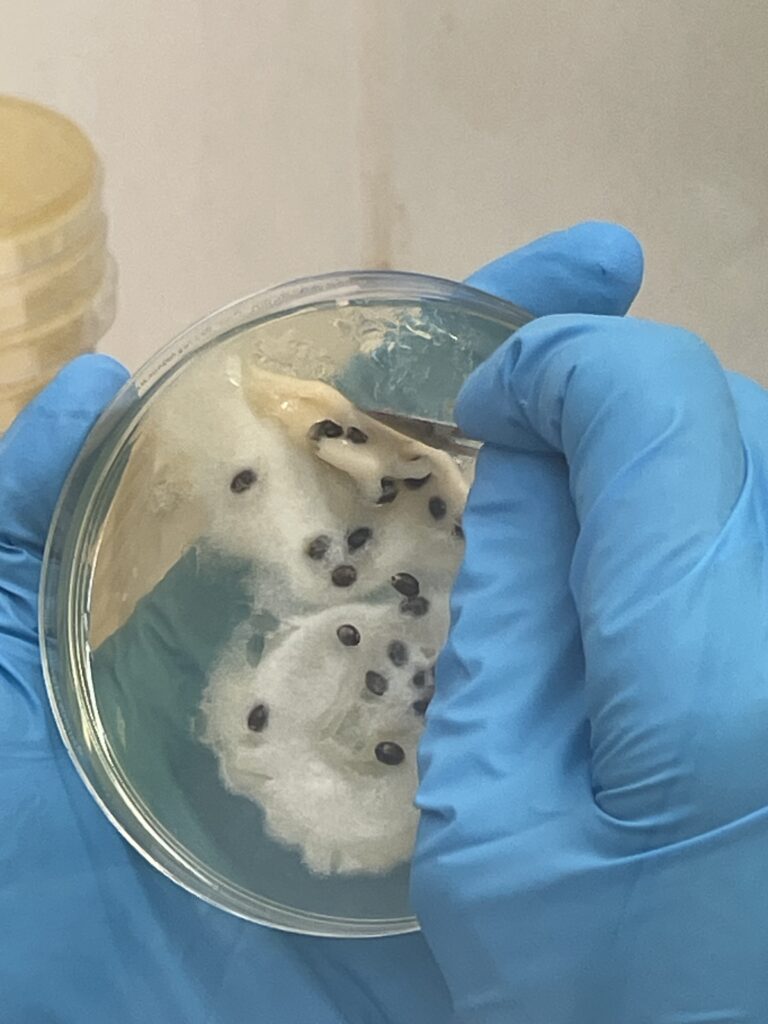

FoU-leder Linda Andersen ved ILAB presenterte i januar resultater fra et nylig gjennomført smitteforsøk på Red Skin Disease (RSD) hos laks. Forsøket ble gjennomført ved ILAB i perioden november–desember 2025.
Studien er et samarbeid mellom ILAB og Fiskesykdomsgruppen ved Universitetet i Bergen (Are Nylund, Heidrun Nylund, Christiane Trösse, Lindsey Moore og Erwan Lagadec), og er støttet av Halden kommune og Haldenvassdraget vannområde.
Red Skin Disease har hatt ukjent årsak siden den først ble beskrevet i Nord-Europa i 2014, og har siden 2019 vært påvist i Norge – særlig i Enningdalselven i Østfold. Sykdommen kjennetegnes av hudblødninger og sårdannelser hos villaks, og flere mulige agens har vært assosiert med tilstanden uten at årsakssammenhengen har vært avklart.
I dette forsøket ble det undersøkt om en ko-infeksjon mellom ulike Aeromonas-bakterier og den parasittiske eggsporesoppen Saprolegnia parasitica kunne reprodusere sykdomsbildet. Ved smitte av kjønnsmodne hannlaks (1–3 kg) ble det observert sykdomsforandringer forenlige med RSD. Resultatene peker særlig på at Saprolegnia parasitica kan ha en viktigere rolle i sykdomsutviklingen enn tidligere antatt.
Presentasjonen samlet stor interesse, med ca 40 deltakere fra et bredt spekter av aktører – inkludert statsforvaltere, Veterinærinstituttet, Miljødirektoratet, flere vannområder (bl.a. Gaula og Numedalslågen), kommuner, jeger- og fiskeforeninger, forskningsmiljøer (NINA, NMBU, UiB), samt grunneiere og andre interessenter.
Det arbeides nå videre med finansiering og etablering av et forskningskonsortium ledet av Haldenvassdraget vannområde ved Lars Selbekk.
Linda Andersen presenterte også arbeidet under Kultiveringsseminaret 2026 (KAF) i Trondheim 16.–18. mars. Bildene under viser oppdyrking av Saprolegnia parasitica, og en villaks med Red skin disease (foto: Bjarne Granli).